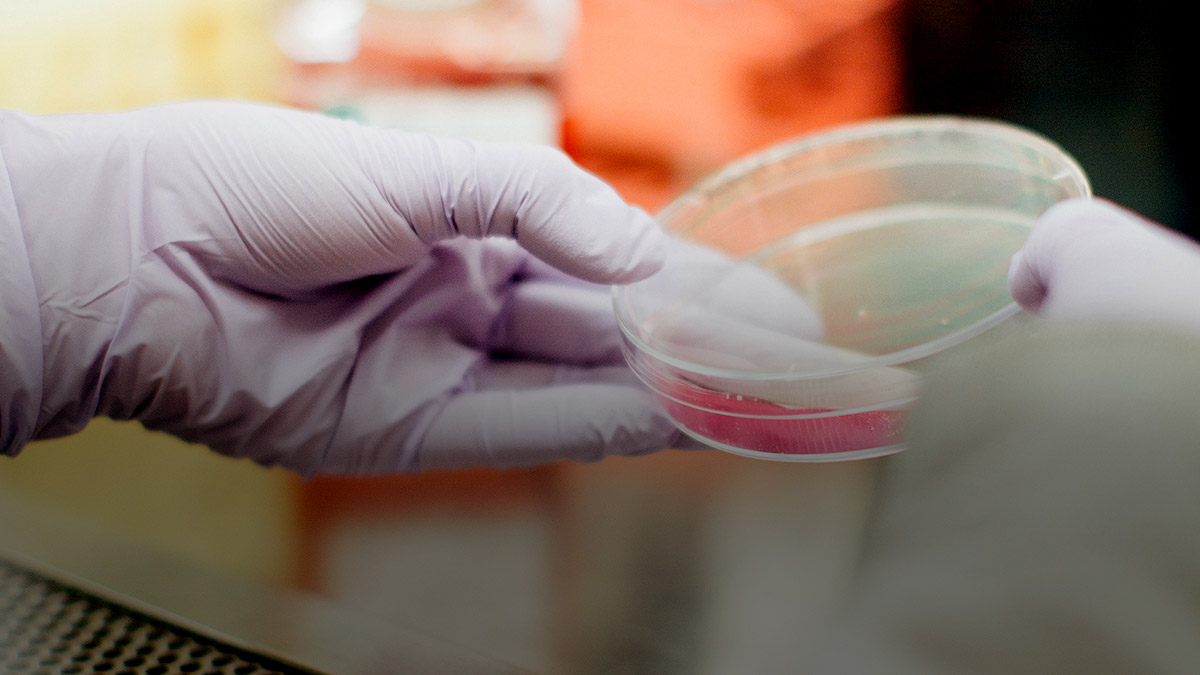
vaccines-story-banner-desktop.jpg

Without fear of disease, vaccine rejection spreads like a contagion.

Without fear of disease, vaccine rejection spreads like a contagion.
It had rained the night before and the pockmarked roads were awash in mud. Their precious cargo could save lives in the remote village at the end of their journey, so the team drove slowly under a cloudless sky. They passed vast tracts of wheat and corn. A herd of zebras grazed on the open savannah.
As they rounded a corner, their tires got caught in the muck, spinning uselessly. Mud flew. They were stuck.
Justin Naiguek patted the cooler in the seat next to him reassuringly. The ice packs would keep the vaccine vials cold for a few hours. Ambulances are a rare sight on Narok’s rural roads in the southwest corner of Kenya, so this one drew a crowd. A group from a nearby village appeared and quickly rallied, pushing with all their might to haul the vehicle out of the mire.
A few kilometers down the road, the ambulance rumbled into Irkaat, a community of 1,800 people. Naiguek, a nurse at nearby Baraka hospital, was there as part of a mobile health clinic, treating patients who are too far or too sick to travel to the hospital.
Back at Baraka, mothers—and it’s almost universally mothers—from Maasasi, Kipsigi and Kisii communities line up early, some having walked for miles with young children in tow to arrive before the clinic opens. They catch up joyfully with friends in a social scene far from the quiet doctors’ waiting rooms we see here in Canada, where surly patients avoid eye contact. Mobile clinics run by Baraka healthcare workers, like the one Naigeuk oversees in Irkaat, bring vaccines to community members to ensure that every last child is protected.
The Kenyan government began mandating vaccinations in the 1980s, targeting the six most common childhood diseases: polio, tuberculosis, diphtheria, whooping cough, tetanus and measles. The program has virtually eradicated illnesses that used to claim thousands of lives.
That success helps explain why people pour out of their homes to greet him when Naiguek visits and children run alongside the ambulance.
We’re having a much different conversation around vaccines in North America. While researchers at McMaster University just unveiled a cutting-edge technology that can deliver vaccines to remote corners of the world without refrigeration, people closer to home are now skeptical. A cultural movement has dawned, one more afraid of inoculations than the diseases they prevent, that’s led to the worst measles outbreak in decades across the United States and the threat of a similar pattern in Canada.
The reason for the discrepancy is obvious: vaccines are a victim of their own success.
The signs of the diseases vaccines fight are still common in Kenya. The government features survivors of polio and measles in awareness campaigns while village elders still bear the ravages of the illnesses. There’s a healthy awareness and fear, born of proximity to disease.
That proximity has been erased in the Global North. In its place, our lack of fear has led to complacency, which has allowed conspiracy theories to take root. While Kenyans walk for miles to their nearest clinics or greet mobile nurses like heroes, we have a new contagion to deal with: denial. Soon, we’ll be back to fear again.


Craig Kielburger is co-founder of the WE Movement, which includes WE Charity, ME to WE Social Enterprise and WE Day.

